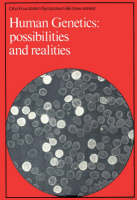
Ciba Foundation Symposium 66 &ndash; Human Genetics &ndash; Possibilities and Realities -  Ciba Foundation

Ciba Foundation Symposium 66 – Human Genetics – Possibilities and Realities
Seiten
2008
Wiley-Blackwell (Hersteller)
978-0-470-72048-6 (ISBN)
Wiley-Blackwell (Hersteller)
978-0-470-72048-6 (ISBN)
- Keine Verlagsinformationen verfügbar
- Artikel merken
The Novartis Foundation Series is a popular collection of the proceedings from Novartis Foundation Symposia, in which groups of leading scientists from a range of topics across biology, chemistry and medicine assembled to present papers and discuss results. The Novartis Foundation, originally known as the Ciba Foundation, is well known to scientists and clinicians around the world.
Ruth Porter is the editor of Human Genetics: Possibilities and Realities, published by Wiley. Maeve O'Connor is the editor of Human Genetics: Possibilities and Realities, published by Wiley.
| Erscheint lt. Verlag | 30.5.2008 |
|---|---|
| Verlagsort | Hoboken |
| Sprache | englisch |
| Maße | 150 x 250 mm |
| Gewicht | 666 g |
| Themenwelt | Naturwissenschaften ► Biologie ► Genetik / Molekularbiologie |
| ISBN-10 | 0-470-72048-4 / 0470720484 |
| ISBN-13 | 978-0-470-72048-6 / 9780470720486 |
| Zustand | Neuware |
| Informationen gemäß Produktsicherheitsverordnung (GPSR) | |
| Haben Sie eine Frage zum Produkt? |